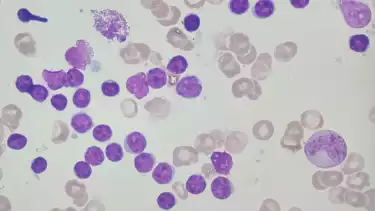

Leukemia Limfositik Kronis: Gejala, Penyebab, dan Pengobatannya
- Pexels/Anna Tarazevich
Jakarta - Leukemia Limfositik Kronis (LLK) atau Chronic Lymphocytic Leukemia (CLL) adalah salah satu jenis kanker darah yang ditandai oleh akumulasi sel-sel limfosit matur monoklonal di sumsum tulang, darah perifer, dan organ-organ limfoid sekunder seperti kelenjar getah bening, liver, dan limpa.
Leukemia Limfositik Kronis atau LLK banyak ditemukan di negara-negara barat dibandingkan negara-negara asia, termasuk Indonesia. Pasien-pasien LLK pada umumnya berusia di atas 50-70 tahun, dan pria lebih banyak menderita CLL dibandingkan Wanita.
Gejala dan Tanda Klinik LLK
Gejala dan tanda klinik LLK beragam. Sebagian kasus LLK tidak menimbulkan gejala.
"Gejala dan tanda klinik LLK yang aktif adalah demam berkepanjangan, keringat malam, penurunan berat badan yang bermakna," ujar dr. Wulyo Rajabto SpPD KHOM, Konsultan Hematologi-Onkologi Medik Departemen Ilmu Penyakit Dalam RSCM/FKUI.
Menurut Wulyo, saat pemeriksaan fisik, dokter bisa menemukan pembesaran kelenjar getah bening, splenomegaly (pembesaran limpa) dan hepatomegaly (pembesaran liver).
Pemeriksaan laboratorium yang khas adalah leukositosis (peningkatan jumlah sel-sel darah putih, bahkan bisa mencapai di atas 100.000/uL) dan limfositosis (akumulasi sel-sel limfosit matur).
Penyebab LLK
Faktor penyebab kanker, termasuk LLK, kata dr. Wulyo, melibatkan lebih dari satu faktor.
"Penyebab kanker multifaktorial, tidak ada satu yang pasti. Usia semakin tua, radiasi, tempat tinggal (geografis orang barat lebih banyak yg LLK dibandingkan orang asia), makanan, polusi semua bisa saling memperkuat dan berpotensi menyebabkan mutasi/gangguan di tingkat kromosom. Sehingga terjadilah perubahan struktur dan sifat sel. Bisa berubah tidak terkendali menjadi tumor ganas," kata dr. Wulyo menjelaskan.
Dia menambahkan, penyebab kanker adalah adanya mutasi di tingkat kromosom dan pemicunya bisa berbagai macam faktor.
Bagaimana Dokter Memastikan Diagnosis LLK?
Untuk menegakkan diagnosis LLK, dokter akan melakukan bone marrow aspiration (aspirasi cairan sumsum tulang) kemudian memeriksa cairan sumsum tulang tersebut di bawah mikroskop.
"Pemeriksaan canggih lainnya adalah pemeriksaan immunophenotyping darah perifer atau cairan sumsum tulang, pemeriksaan kromosom, dan pemeriksaan interphase FISH (Fluorescent insitu hybridization), bergantung kemampuan laboratorium di rumah sakit masing-masing," jelas dokter yang juga Staf Divisi Hematologi-Onkologi Medik RSCM ini.
Load more